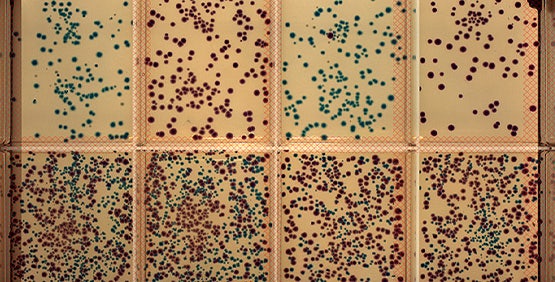

Microbiome Research
Agricultural biotechnology increasingly relies on microbiome research to improve soil health, crop resilience, and sustainable yields. From screening beneficial microbes to understanding complex microbial interactions, microbiome studies play a critical role in developing next-generation agricultural solutions.
Explore how automated screening, imaging, and data analysis support microbiome research—from discovery through scale-up.
Learn more about Microbiome research